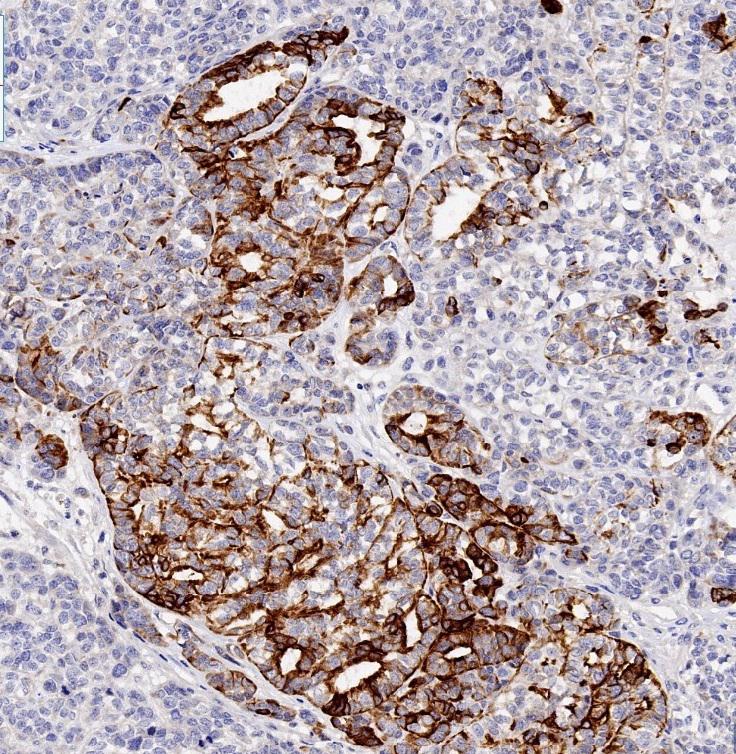

2. 杭州师范大学附属医院病理科,杭州 310015
青年脑卒中是指35岁以下的青年人发生的脑卒中,其中以缺血性卒中为主,出血性脑卒中相对较少。其中病因主要以颅内动静脉畸形、血管瘤为主,脑肿瘤合并出血少见。现报道1例20岁女性患者,近1月来头疼眩晕伴右侧肢体麻木,突发昏迷,影像发现颅内占位伴出血急诊手术。现将诊治经过报道如下。
1 资料与方法患者女,20岁,既往无殊,近1个月来感觉眩晕、头疼及右侧肢体麻木,间断性恶心伴呕吐,未予重视,1 d前突发昏迷,呼之不应,急至当地医院头颅MRI检查。发现左侧顶枕叶不均匀强化肿块伴出血,肿块周围明显水肿,中线受压移位,病变大小6.0 cm×4.4 cm×3.5 cm。病变位于脑实质内,影像学考虑恶性肿瘤伴出血。患者于2021年2月在当地医院急诊手术,切除大部分肿瘤及清除血块。术后患者曾多处会诊,病理结果较难统一,病理诊断包括转移性低分化癌、转移性黑色素瘤、中枢神经系统胚胎性肿瘤、恶性混合性生殖细胞肿瘤、间变性室管膜瘤等诊断,后病理切片及蜡块送至浙江大学医学院附属第二医院会诊。
显微镜下可见肿瘤组织形态多样,排列成片状、巢团状,腺样、乳头样、小梁状等特征(图 1~4),肿瘤细胞呈上皮样,细胞核大,细胞浆丰富,部分细胞浆透明,染色质粗大,可见小核仁,肿瘤内有大片凝固性坏死及出血。免疫组化结果显示CKp局灶+(图 5),EMA局灶+,CK8/18局灶+,Vimentin弥漫+,CD56弥漫+,NSE局灶+,CgA-,Syn-,SOX-10-,D2-40-,S100-,GFAP-,IDH1-, CD30-,NeuN-,NF-, Olig2-,CD117-, CD99-, SALL4-, HCG-, PLAP-, Calretnin-, WT1-, CD10-, CD31-, CD34-, MyD1-, AFP-, ER-, PR-, HMB45-, melanA-, SMARCB1/INI-1+, SMARCA2/BRM-, Ki67约40%(图 6)。

|
| 图 1 肿瘤细胞排列成实性巢团样,细胞核形状不规则,染色质浓密,有小核仁,细胞浆丰富透明HE(染色,中倍镜) |
|
|

|
| 图 2 部分区域肿瘤形成复杂的乳头状结构(HE染色,中倍镜) |
|
|

|
| 图 3 部分区域肿瘤形成复杂的乳头状结构(HE染色,中倍镜) |
|
|

|
| 图 4 肿瘤具有明显的小梁状结构(HE染色,中倍镜) |
|
|
|
| 图 5 免疫组化CKp见部分肿瘤细胞呈异质性表达 |
|
|

|
| 图 6 Ki67约30% 肿瘤细胞表达 |
|
|
目前的免疫组化结果提示,该肿瘤仅具有部分区域的上皮分化,但高级别胶质瘤、神经母细胞瘤、恶性黑色素瘤、生殖细胞肿瘤、不典型畸胎样/横纹肌样肿瘤等均可排除。但该患者为20岁的年轻人,转移癌较罕见,后续体检中也未见其他部位肿瘤,转移性低分化癌基本排除。为进一步明确组织学分类及归属,对该患者组织样本进行NGS检测,结果显示该肿瘤存在同源重组修复(homologous recombination repair,HRR)通路上多个基因的拷贝数缺失,杂合性缺失比例达到51.31%,提示该肿瘤为HRR缺陷型肿瘤。但测序结果仍未能提供肿瘤的明确分化及分类。
随后对该患者样本进行DNA甲基化检测(Illumina EPIC array),将该肿瘤甲基化模式与82种脑肿瘤(www.molecularNeuropathology.org; Classifier Version V11b4) 对比后,结果最符合中枢神经系统高级别神经上皮性肿瘤伴MN1异位(分类评分类似度0.99,分类评分cutoff 0.9)。与NGS结果类似的是肿瘤内具有大量基因拷贝数的缺失和获得、无基因扩增、无MGMT启动子甲基化。在2021年第五版WHO中枢神经系统肿瘤分类中,该肿瘤被归入星形母细胞瘤,伴MN1异位。
最终病理诊断:星形母细胞瘤,伴MN1异位。
2 讨论自2016年修订第四版WHO中枢神经系统肿瘤分类以来,通过形态特征、免疫表型和分子遗传学特点,大部分神经肿瘤可得到更为精准的诊断[1]。近五年来,在cIMPACT-NOW的推动下,经过7次更新,2021年第五版中枢神经系统WHO分类出版。该分类强调了分子检测在中枢神经系统肿瘤分类中的价值,增加了许多由于遗传学特征不同而有别于传统组织学类型下的新亚型[2-3]。随着NGS和DNA甲基化检测的应用,仍有一些新近认识的罕见肿瘤从传统组织学类型中被识别出来。本文报道一例星形母细胞瘤,也曾经被命名为中枢神经系统高级别神经上皮性肿瘤伴MN1异位(CNS high grade neuroepithelial tumor with MN1 alteration, CNS HGNET-MN1),通过形态学评估、免疫组化鉴别、NGS和DNA甲基化检测等手段,最终明确了病变的归属,为临床病理的鉴别诊断提供帮助和借鉴,也可能为潜在的靶向治疗提供理论依据。
星形母细胞瘤是一类罕见的中枢神经系统肿瘤,在2016年WHO分类内并不清楚其特征性的遗传学异常。其组织学常形成围绕血管的放射状菊形团,称为“星形母细胞性假菊形团”。在横切面上表现为乳头状或假乳头状结构,类似转移性乳头状癌。在文献报道内也确有肿瘤细胞部分表达上皮性标记物CK, CAM5.2及EMA。在2021 CNS-WHO分类以前,伴MN1异位的星形母细胞瘤也被称为伴MN1异位的中枢神经系统高级别神经上皮肿瘤[4],儿童及青少年相对常见,肿瘤一般位于幕上,中位年龄16岁(年龄范围5~40岁),女性发生为主,存在转录共调节因子MN1的融合基因,大部分MN1异位形成MN1-BEND2或MN1-CXXC5融合基因,约60%的病例具有染色体X的拷贝数缺失[5-6]。但在本次报道的这例病变内,肿瘤细胞几乎无胶质细胞分化(不表达GFAP),而更加类似转移癌,在免疫表型上也可发现肿瘤细胞部分具有上皮样分化(CKp, CK8/18部分表达)。如果该病例发生在年龄较大的成年人,基本会诊断为来源不明的转移性低分化癌,而不会进行详细的遗传学检查。由于星形母细胞瘤相对罕见,因此,在目前的WHO分类中还没有明确的组织学分级。但是,组织学明确具有的恶性特征,如明显的细胞学间变特征、核分裂和坏死,都与复发、肿瘤进展和预后差相关,因此不同的组织学特征,可能仍具有不同的预后意义,应该与分化较好的星形母细胞瘤被区别对待[7]。
在过去十年中,DNA甲基化状态分析已经成为CNS肿瘤分类的有效方法[8-9]。但甲基化分析的最佳方法和质控尚未能完全统一,该技术也未能如PCR、FISH或NGS那样广泛开展。但是WHO第五版分类假定大部分CNS肿瘤具有特征性的甲基化谱,当需要依靠甲基化进行分类时,这些甲基化特征将被包含在此类肿瘤的定义中。对于形态学典型的成人浸润性胶质瘤,免疫组化抗体筛查及适当的分子检测,可对绝大部分脑肿瘤进行分级和分类。儿童脑肿瘤由于发生机制与成人不同,免疫组化检测基本不能提示明确的诊断信息。年轻成人的脑肿瘤比较复杂,既可发生成人型的脑肿瘤,也可发生儿童型脑肿瘤。对于2021分类中的新提出的脑肿瘤亚型,基本都需要非常规检测才能得到正确诊断。在形态学特征为典型的星形母细胞瘤内,约70%的病例可检测到MN1异位;但星形母细胞瘤特征性的DNA甲基化模式,比MN1异位更具有特异度,可将星形母细胞瘤与形态类似的具有星形母细胞样菊形团的脑肿瘤可靠鉴别,临床病理医师选择合适的检测方法是避免误诊少见肿瘤的关键。
该患者在肿瘤大部切除后未进行辅助放化疗,10个月后肿瘤复发,于当地医院二次手术切除,提示该肿瘤具有明显侵袭性,类似WHO 4级肿瘤的生物学行为,目前仍在随访中。在Baroni等[10]报道的14例具有高级别特征的病例中,尽管所有患者都进行了全切/次全切,大部分患者在术后都进行了辅助放化疗,但是50%的患者术后复发,提示这类肿瘤需要临床积极的治疗措施。从该病例的诊疗过程来看,青年出血性卒中的原因,需要考虑到脑肿瘤的可能。
利益冲突 所有作者声明无利益冲突
作者贡献声明 李百周:论文撰写和鉴别诊断;杨文君:组织学评估;赵敏:资料收集整理
| [1] | Louis DN, Ohgaki H, Wiestler OD, et al. The 2007 WHO classification of tumours of the central nervous system[J]. Acta Neuropathol, 2007, 114(2): 97-109. DOI:10.1007/s00401-007-0243-4 |
| [2] | Louis DN, Perry A, Wesseling P, et al. The 2021 WHO classification of tumors of the central nervous system: a summary[J]. Neuro Oncol, 2021, 23(8): 1231-1251. DOI:10.1093/neuonc/noab106 |
| [3] | WHO classification of tumor editorial board. Central nervous system tumors. WHO classification of tumor[M]. 5th edition. IARC, YON, 2021. |
| [4] | Sari R, Altinoz MA, Ozyar E, et al. A pediatric cerebral tumor with MN1 alteration and pathological features mimicking carcinoma metastasis: may the terminology "high grade neuroepithelial tumor with MN1 alteration" still be relevant?[J]. Childs Nerv Syst, 2021, 37(10): 2967-2974. DOI:10.1007/s00381-021-05289-3 |
| [5] | Louis DN, Wesseling P, Aldape K, et al. cIMPACT-NOW update 6:new entity and diagnostic principle recommendations of the cIMPACT-Utrecht meeting on future CNS tumor classification and grading[J]. Brain Pathol, 2020, 30(4): 844-856. DOI:10.1111/bpa.12832 |
| [6] | Hirose T, Nobusawa S, Sugiyama K, et al. Astroblastoma: a distinct tumor entity characterized by alterations of the X chromosome and MN1 rearrangement[J]. Brain Pathol, 2018, 28(5): 684-694. DOI:10.1111/bpa.12565 |
| [7] | Wood MD, Tihan T, Perry A, et al. Multimodal molecular analysis of astroblastoma enables reclassification of most cases into more specific molecular entities[J]. Brain Pathol, 2018, 28(2): 192-202. DOI:10.1111/bpa.12561 |
| [8] | Tauziède-Espariat A, Pagès M, Roux A, et al. Pediatric methylation class HGNET-MN1:unresolved issues with terminology and grading[J]. Acta Neuropathol Commun, 2019, 7(1): 176. DOI:10.1186/s40478-019-0834-z |
| [9] | Kumar R, Liu APY, Orr BA, et al. Advances in the classification of pediatric brain tumors through DNA methylation profiling: from research tool to frontline diagnostic[J]. Cancer, 2018, 124(21): 4168-4180. DOI:10.1002/cncr.31583 |
| [10] | Baroni LV, Rugilo C, Lubieniecki F, et al. Treatment response of CNS high-grade neuroepithelial tumors with MN1 alteration[J]. Pediatr Blood Cancer, 2020, 67(12): e28627. DOI:10.1002/pbc.28627 |
 2022, Vol. 31
2022, Vol. 31


